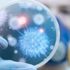

MORE IN SAĞLIK»

Bebekler anne karnında görebilir mi?
03 Mayıs 2017 14:49
İthal ürün 6'da 1 maliyetle Diyarbakır'da üretildi
03 Mayıs 2017 14:49
Obezite cerrahisi kanser riskini azaltır mı?
03 Mayıs 2017 14:49 resimsizTrafik kazalarında 2016'da 7 bin 300 kişi öldü
03 Mayıs 2017 13:56
Tırnakta beyaz ve sarı renkleri önemseyin
03 Mayıs 2017 13:46
Şırnak'ta 2 terörist teslim oldu
03 Mayıs 2017 13:05
Ellerinizi yıkamadan asla kulaklarınıza dokunmayın!
03 Mayıs 2017 11:46
Dünyada yaklaşık 300 milyon astım hastası var
03 Mayıs 2017 10:51
Dünya Sağlık Örgütü 6. ofisini İstanbul’da açacak
03 Mayıs 2017 09:45
Astımlı için zor günler
03 Mayıs 2017 05:47HOTTEST NEWS IN SAĞLIK»
WHAT'S NEW IN SAĞLIK»
- Pfizer'ın koronavirüs hapı için lisans anlaş…
- Belçika'da aşı yaptırmayan sağlık personelin…
- Kepez DokumaPark'ta botanik bahçe açıldı
- Kayapınar Belediyesi'ne ‘TS EN ISO 9001 Kali…
- Manisa'da prestij cadde düzenlemeleri sürüyor
- Serik'te trafik kazası : 3 yaralı
- Karantinayı ihlal eden 2 kişi trafik uygulam…
- Kıbrıs Gazisi Yılmaz son yolculuğuna uğurlan…
- Ormanda üzerine ağaç devrilen Hakan öldü
- Burcu Esmersoy'un akşam yemeği şıklığı
- Pfizer, Kovid-19'a karşı ağızdan alınan ilaç…
- Covid-19'a yakalanan hamilelerde erken doğum…
- AB Adalet Divanı'ndan yargı bağımsızlığı kon…
- Doğumu kolaylaştıran yeni teknik literatüre …
- Sivas'ta doğumu kolaylaştıran teknik: Bilim …
- Türkiye'nin koronavirüs aşılama kampanyası k…
- Corona aşısından sonra sıra kanserde
- Koronavirüs erken doğum riskini arttırıyor
- "Fazla dezenfektan cilt kuruluğuna neden olu…
- Bilim Kurulu üyesinden 3. doz açıklaması!


